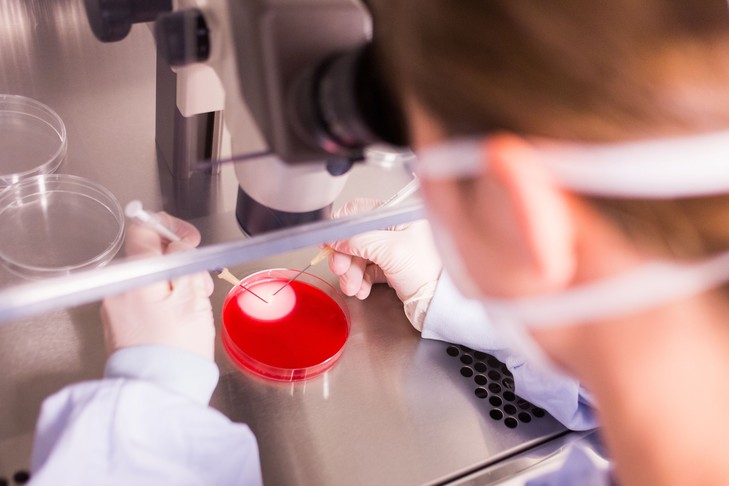
Image - La Croix : « Le gouvernement entend ouvrir la PMA « à toutes les femmes » »

Mardi 12 septembre, la secrétaire d’État Marlène Schiappa a confirmé que le gouvernement proposerait l’ouverture de la procréation médicalement assistée aux couples de femmes et aux célibataires dans le cadre de la révision de la loi de bioéthique prévue en 2018.
Dans le domaine de la procréation médicalement assistée (PMA), l’exécutif affiche sa détermination. Mardi 12 septembre, sur RMC, la secrétaire d’État à l’égalité entre les femmes et les hommes, Marlène Schiappa, a confirmé que le gouvernement proposerait « d’ouvrir la PMA à toutes les femmes » dans le cadre de la révision des lois de bioéthique prévue en 2018. Cette déclaration intervient après celle de sa collègue Agnès Buzyn, ministre de la santé, qui avait estimé début juillet que « la France [était] prête » à un tel élargissement, alors que le droit français réserve aujourd’hui ces techniques aux couples hétérosexuels en âge de procréer, souffrant d’une infertilité médicale.
En elles-mêmes, ces déclarations n’ont rien de surprenant. Dès la campagne présidentielle, le candidat Macron s’était dit convaincu, à titre personnel, de la nécessité d’étendre la PMA, tout en précisant qu’il « respectera [it] l’avis du Comité consultatif national d’éthique ». Depuis lors, en juin, cette instance a publié un avis favorable à l’« ouverture de l’insémination artificielle avec donneur à toutes les femmes », couples de lesbiennes ou femmes célibataires, au nom de leur souffrance et de l’évolution de la société. Il était donc logique que le gouvernement avance ses pions.
Source :
Marine Lamoureux, le 12/09/2017 à 16h33
http://www.la-croix.com/Sciences-et-ethique/Ethique/Le-gouvernement-entend-ouvrir-PMA-toutes-femmes-2017-09-12-1200876233